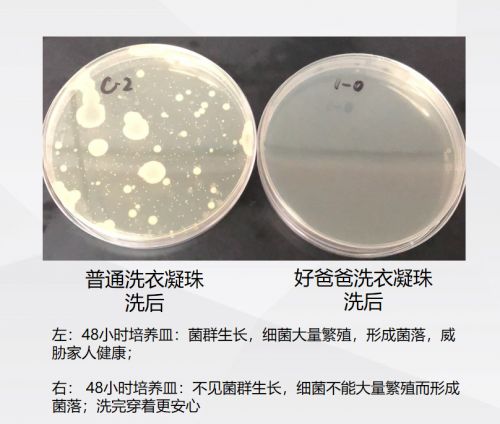

洗衣凝珠哪个牌子好?这款酵素洗衣凝珠为你解决洗衣困扰
5盖洗衣液,不如1颗洗衣凝珠。作为第四代洗衣革命的洗衣凝珠,早在欧洲就有超三千万家庭使用,平均1.1秒就有一颗卖出。要说洗衣凝珠哪个牌子好,不得不全方位考量。面对一堆脏衣服,手洗嫌懒又怕伤手,全部机洗又怕洗不干净。特别是家里有男生和小朋友的,运动后衣服都是汗,遇上阴雨天气,晒过的衣服还有股闷闷的味道,穿在小朋友身上也会不舒服。普通洗衣液很难清洗干净,因为清洁力不够强,也没有杀菌效果。直到小编发现了这款天然酵素亲肤洗衣凝珠,清洁、除菌力很强,只要小小一颗,就能洗净全家人的衣物。这款洗衣凝珠来自好爸爸,是专为有孩家庭研制的高端亲肤洗护品牌,采用温和成分,不添加、不残留有害物质,更适合孩子。

洗衣凝珠哪个牌子好?看净衣效果
小朋友们贪玩,衣服上总是会有很多污渍,用一般的洗涤用品清洗会比较费劲。传统洗衣粉或洗衣液的量常常控制不好,每次放太少担心孩子衣服洗不干净,清洁不干净的污垢会生成细菌;放太多了有时候又担心化学物质残留会对孩子的健康不利。好爸爸天然酵素亲肤洗衣凝珠添加丹麦进口的天然酵素,运用了创新粉液分离技术,让酵素保留强大活力,深入衣物纤维。而其中添加的无水枸橼酸钠可以络合金属离子,提升洁净效能,防止微沉积。
1颗洗衣凝珠可洗6-18件衣物,清洗衣物更干净。用它洗过的衣物,即使在梅雨天或室内晾晒也干净如新。
洗衣凝珠哪个牌子好?看除菌能力
除了基本的洗衣外,让人满意的还有它的抑菌除螨功效。相比其他普通洗衣凝珠,它有着超强的除菌力,对内外衣物的有效除菌率达到99.9%以上。好爸爸天然酵素亲肤洗衣凝珠能把导致衣服臭臭的细菌都消灭,不用再为衣服发霉发臭而担心。而对有咬衣服习惯的小朋友来说,也不必担心病从口入。
不仅仅是除菌,同时还能抑制螨虫!一般的洗衣液,并不能抑虫,洗完后看似螨虫没了。实际上各种微生物留是潜在纤维空隙中,等你穿上这样洗过的衣服,只要稍微出一点点汗,螨虫们就能迅速卷土重来,继续啃食你的皮屑,让你的肌肤总是瘙痒起痘。好爸爸洗衣凝珠的除螨率高达99%,有效洗除屋尘螨,妈妈们再也不用担心宝宝和猫猫狗狗一起玩耍了。

洗衣凝珠哪个牌子好?看安全程度
好爸爸天然酵素亲肤洗衣凝珠的核心成分之一枸橼酸钠的制备原料来源于粮食,因而绝对安全可靠,对人类健康不会产生危害。而且,这款洗衣凝珠pH值是非常接近人体皮肤的中性,不添加荧光增白剂、漂白剂、防腐剂等,温和低敏不伤皮肤,无污染,安全环保。全家衣物可以放心混洗,真的能成为解放妈妈们的福音!
市场上琳琅满目的洗衣产品层出不穷,平常用洗衣液总控制不好量,用洗衣凝珠后,全家人一桶衣服,只要丢1颗进去就可以搞定,再也不怕把手弄得滑腻腻的。洗衣凝珠哪个牌子好,取决于你追求什么样的清洗效果。衣服每天和肌肤接触,它的质感尤为重要,因而衣服也需要精心的护理。好爸爸天然酵素亲肤洗衣凝珠等于洗衣液+除菌液+除螨液,适合全家使用,温和配方也不会伤肌肤,可以放心用。一直在为宝宝的洗衣用品发愁的妈妈们,可以试试看它。
网址:洗衣凝珠哪个牌子好?这款酵素洗衣凝珠为你解决洗衣困扰 https://www.jiaju82.com/news-view-id-699637.html
